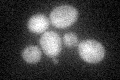
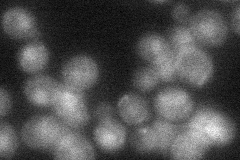
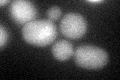
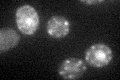

View description
Penta-EF-hand protein required for polar bud growth and cell wall abscission; binds calcium and zinc with different affinity; localizes to bud site in G1, bud neck in G2
Localization:
Intensity:
Fold change:
Significance:
-
C’ GFP library in SD
cytosol24.76 -
N' NOP1pr-GFP in SD

punctate,nucleus68.2124 -
N' TEF2pr-mCherry in SD

punctate,nucleus111.188 -
N' NATIVEpr-GFP in SD
nucleus26.5372 -
N' TEF2pr-VC and Cyto-VN in SD

punctate36.0627 -
C’ GFP library in SD+DTT
cytosol21.720.87No -
C’ GFP library in SD+H2O2

cytosol29.671.19No -
C’ GFP library in Starvation Media
cytosolN/AN/AYes -
C’ GFP library on the background of Pup2-DaMP

N/A -
C’ GFP library on the background of CCT mutant

N/A0N/AYes
